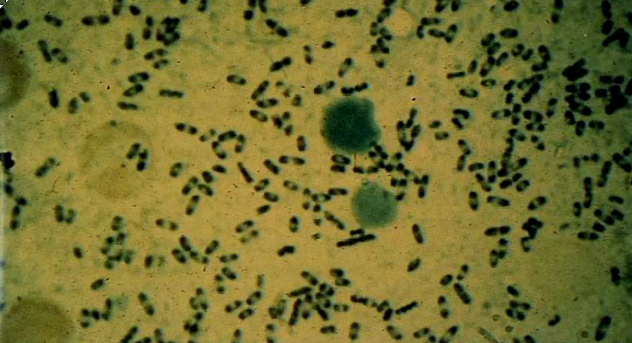

When is anthrax contagious?
Never, the spores are the only contagious form and we don’t produce spores.
Watery diarrhea from Chinese rice sitting out all day
Bacillus cereus spores
Spore-forming gram-positive rods
Bacillus (aerobes) and clostridia (anaerobes). They sporulate from a vegetative rod to a spore and then germinate into a rod (bacillus anthracis chains shown below).

Virulence factors of bacillus anthracis
Poly D-glutamic acid capsule (evades phagocytosis), replicates in blood stream, produces EDEMA TOXIN = edema factor (EF=A subunit) + protective antigen (PA=B subunit), produces LETHAL TOXIN = lethal factor (LF=A subunit) + protective antigen (PA=B subunit).
Antibody to what region of bacillus anthracis neutralizes the toxin?
Anti-PA antibody. This prevents PA from binding to macrophages and forming a pore so the A subunits can enter.

Function of B. anthracis edema factor?
Calmodulin-dependent bacterial adenylate cyclase. Causes fluid accumulation at site of infection. (like pertussis).
Function of B. anthracis lethal factor?
Zinc-metaloprotease that cleaves MAPKK -> disrupts MAPK signal transduction in macrophages -> inactivates macrophages and minimizes immune response.
B. anthracis reservoir
Soil, especially in grazing goats, cattle and sheep hides. Can also get from contaminated meat and IV drug abuse (heroin wrapped in goat skin).
3 manifestations of anthrax

CUTANEOUS (papules -> central necrosis -> black eschar, painless, edematous, resolves 90% of time). GASTROINTESTINAL: ingestion of spore-contaminated meat, ulcers at site of invasion, regional lymphadenopathy, edema, hemorrhage, sepsis, 50% mortality. INHALATIONAL (

Prophylaxis for inhalational anthrax
Ciprofloxacin/doxycycline + clindamycin + rifampin for 60 days!
Licensed anthrax vaccine
Non-encapsulated, attenuated live vaccine
Lab characteristics of the bacteria that causes plague.
Yersinia pestis: gram-negative rod that grows on MacConkey’s agar and stains with Wayson’s stain (looks like safety pins).
Only type of plague that transfers person to person
Pneumonic plague (middle ages), all other plagues need fleas to transfer the bacteria from the reservoir (rats, squirrels, prairie dogs, mice, cats, rabbits) to humans.
Pathogenesis of plague
Flea regurgitates bacteria on bite -> Phagocytosis -> Released from monocytes -> Lymphatics -> Bubo -> Resolution or Dissemination -> Bacteremia w/pneumonia, meningitis and/or septic shock.
